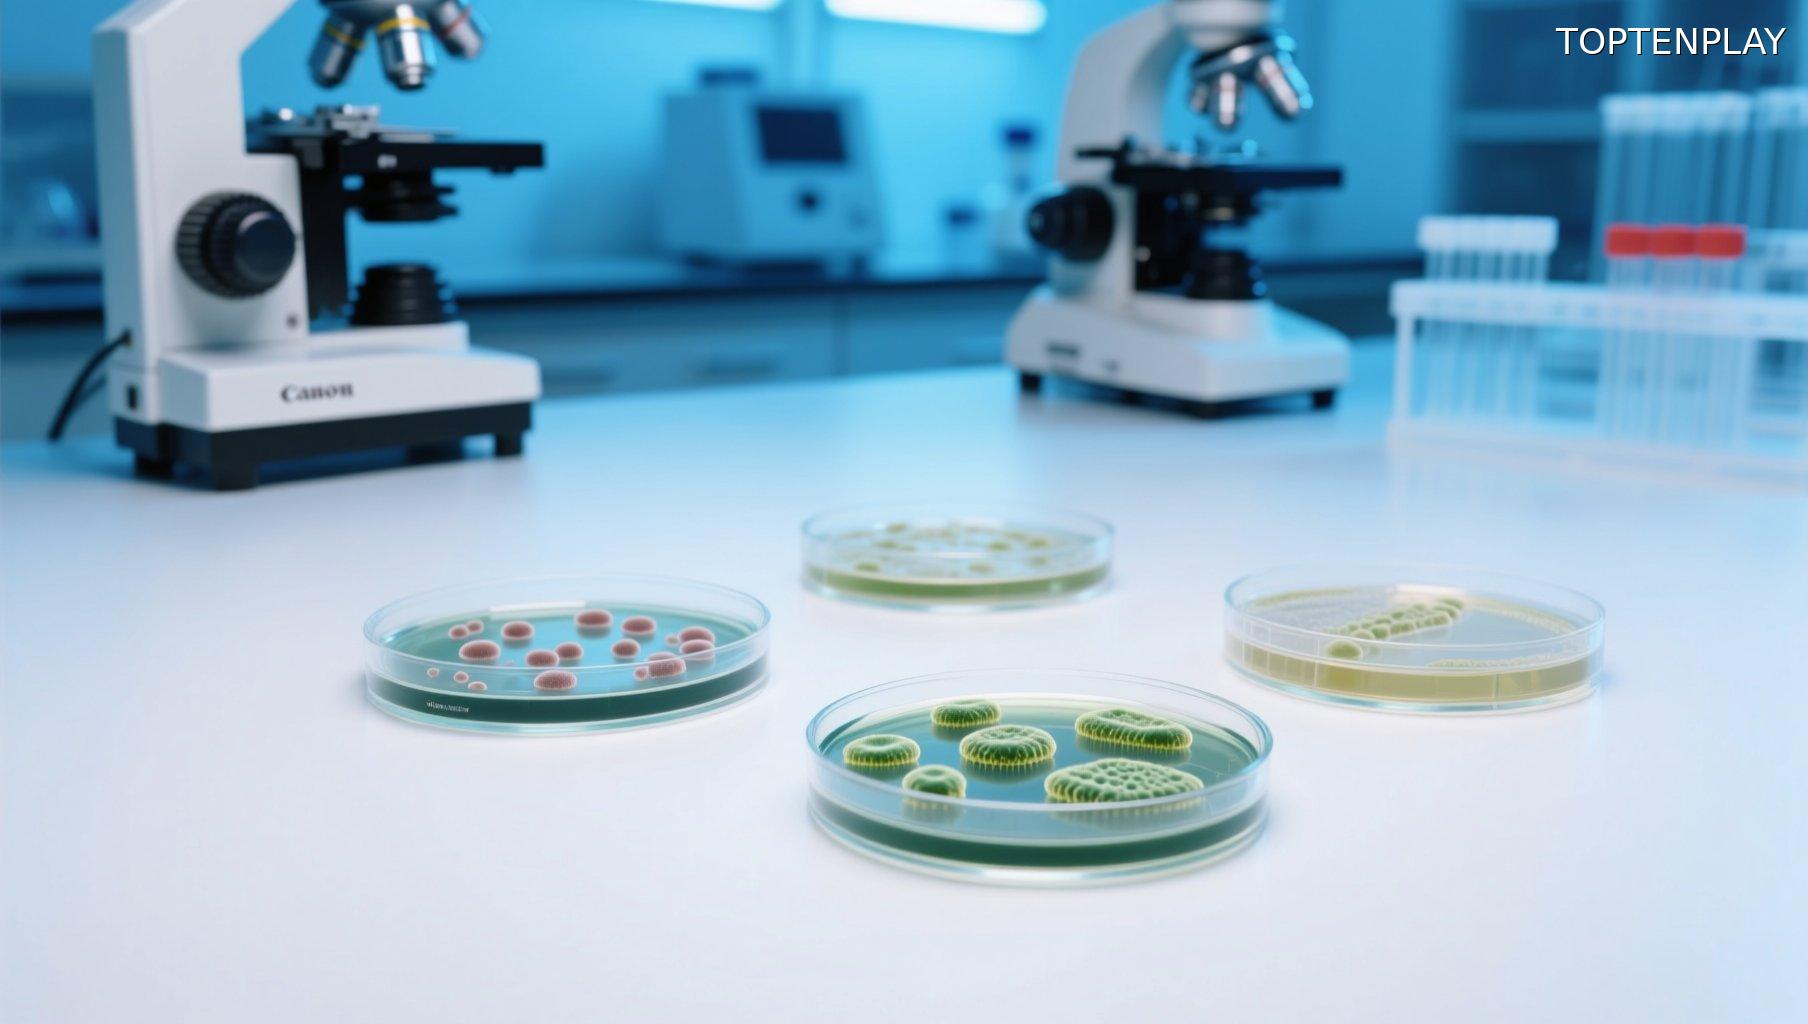
Image d'illustration © TopTenPlay

📌 Cette fréquence aux toilettes révèle l’état de vos reins et de votre foie selon cette étude
Posted 29 octobre 2025 by: Admin
Une étude récente révèle que votre fréquence aux toilettes pourrait être un indicateur surprenant de la santé de vos reins et de votre foie. Des chercheurs ont analysé plus de 1 400 adultes et découvert qu’une fréquence spécifique optimise la santé de ces organes vitaux. Les résultats pourraient transformer votre compréhension du transit intestinal.
Publicité:
Une découverte scientifique bouleverse notre compréhension des signaux que nous…
Publicité:
Voir l'article complet..
Publicité:










